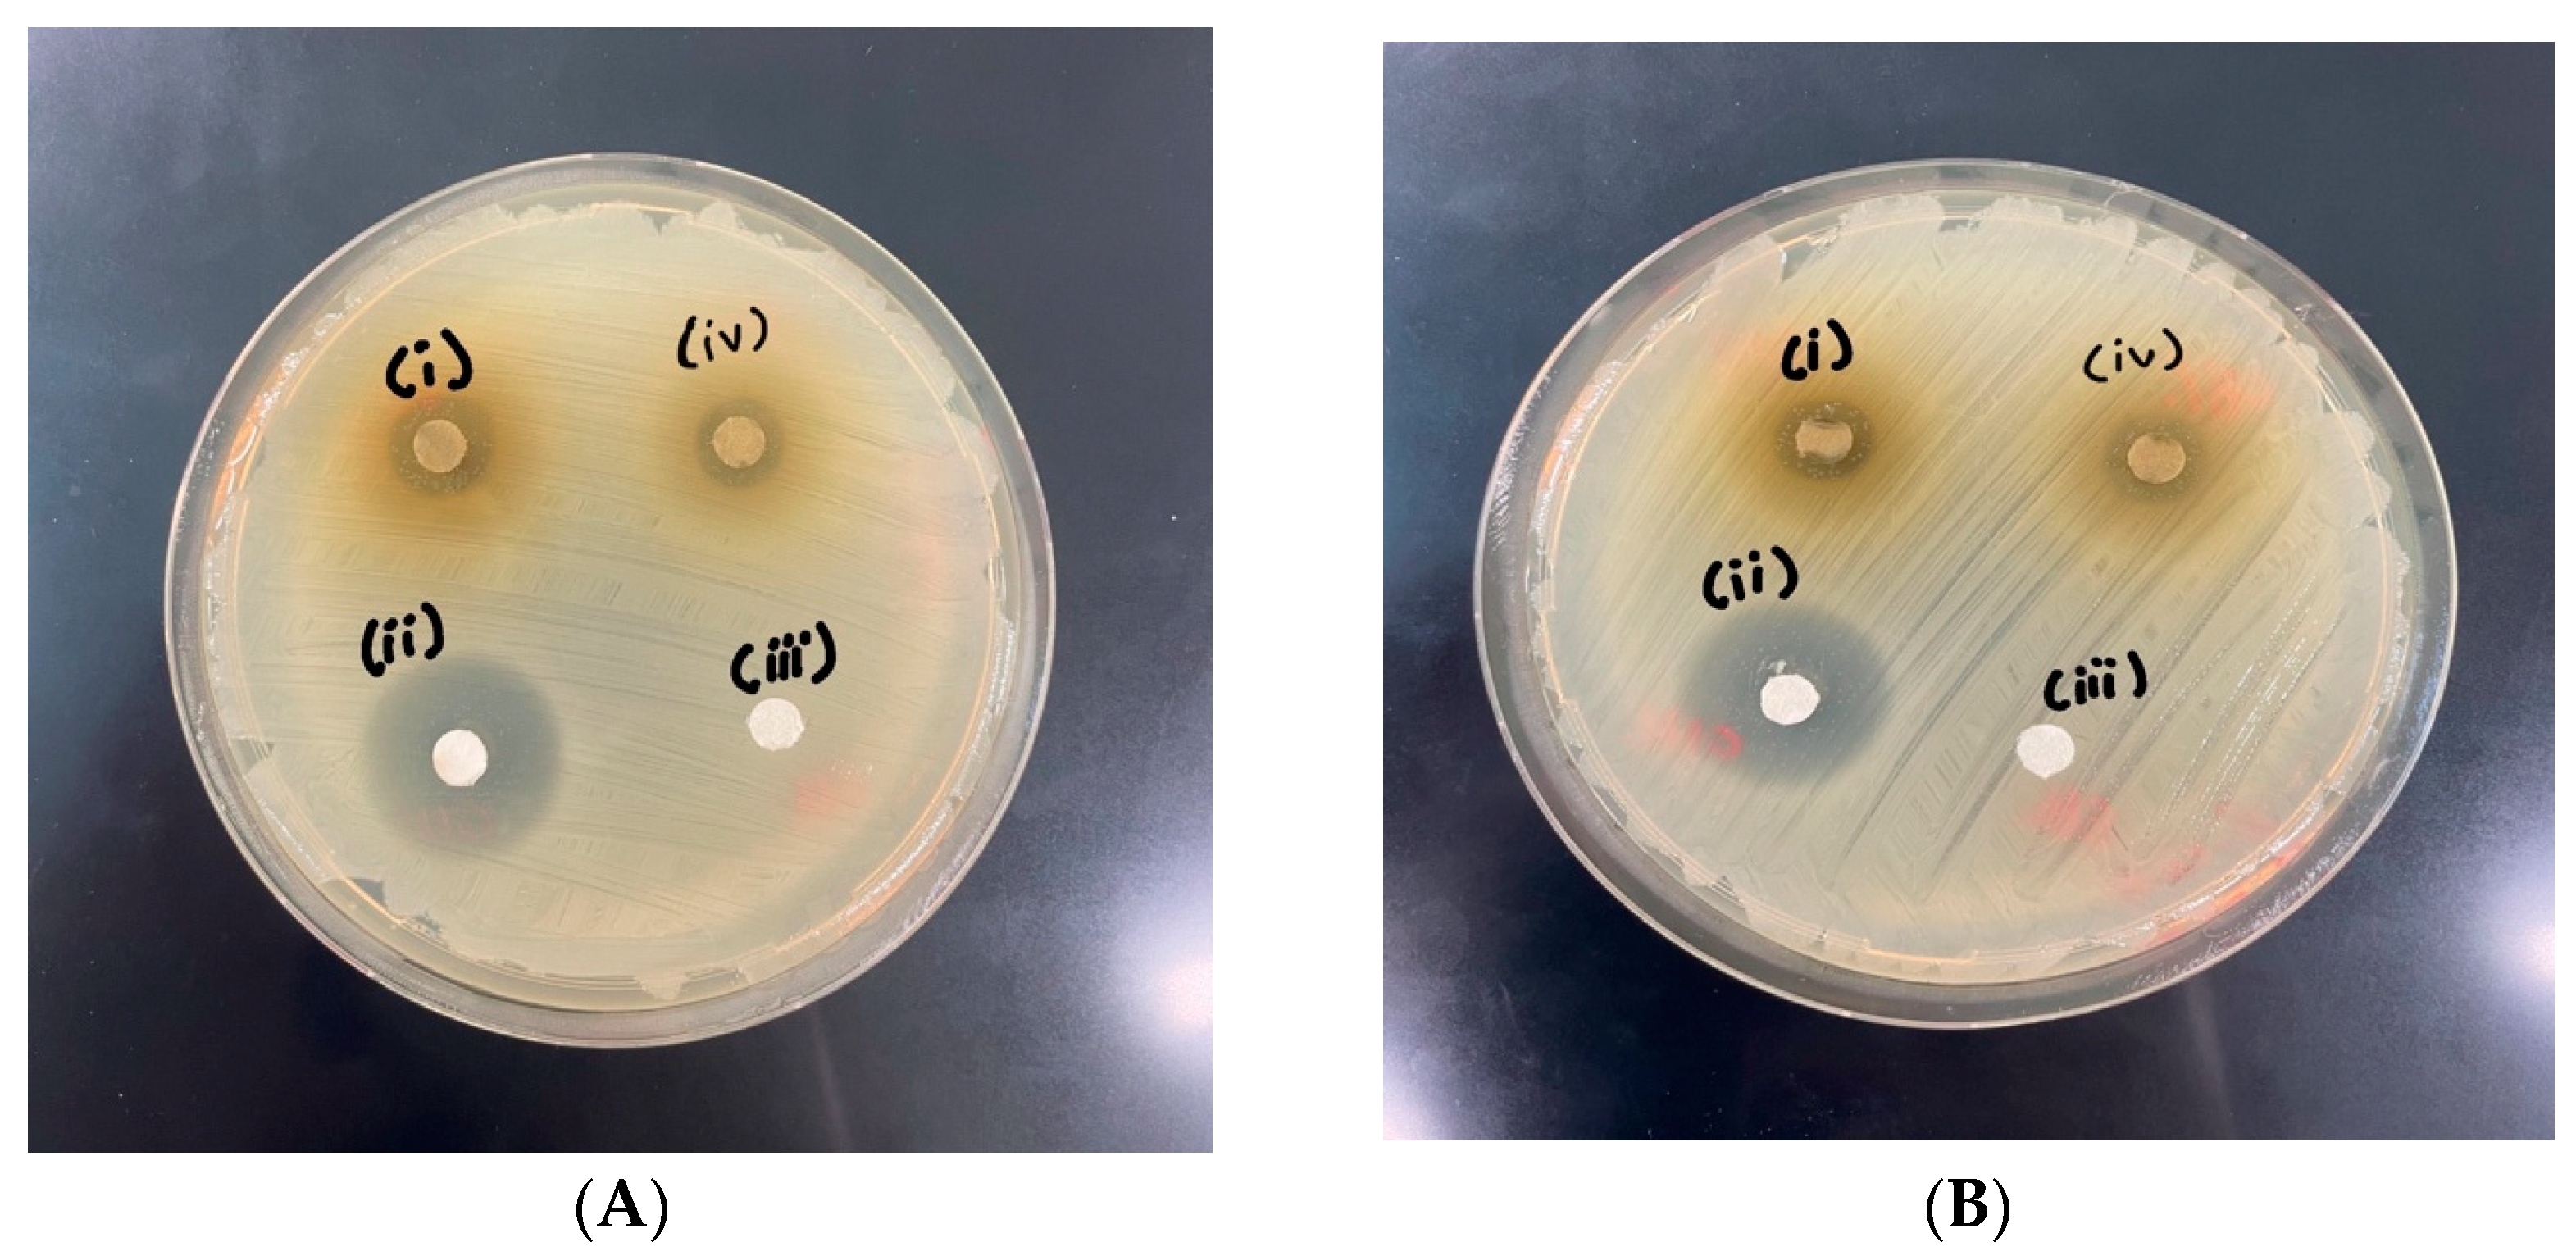
Foods 13 02436 g002

Characterization of Marigold Flower (Tagetes erecta) Extracts and Microcapsules: Ultrasound-Assisted Extraction and Subsequent Microencapsulation by Spray Drying
Abstract
1. Introduction
2. Materials and Methods
2.1. Sample Procurement and Preparation of Marigold Flower Powder
2.2. Response Surface Methodology, Optimization, and Preparation of Marigold Flower Extract
2.3. Antimicrobial Activity of RSM-Optimized MFE
2.3.1. Growth Conditions
2.3.2. Determination of Inhibition Zones of MFE by Minimum Inhibitory Concentration and Disk Diffusion Method
2.4. Microencapsulation of RSM-Optimized MFE in Maltodextrin (MD) and Gum Arabic (GA)
2.5. Physiochemical Properties of MD and GA Microcapsules Loaded with MFE
2.5.1. Determination of Bioactive Compounds (TPC and TFC), Antioxidant Activity (DPPH and FRAP), and Carotenoids of MFE without and with Encapsulation
2.6. Statistical Analysis
3. Results and Discussion
3.1. Optimization of Ultrasound-Assisted Extraction (UAE) of Bioactive Compounds from Marigold Flower Using RSM
3.2. Analysis of Bioactive Properties of MFE
3.3. Impact of Microencapsulation Process on Physicocpemical Properties and Microstructure of MFE Microcapsules
3.3.1. Physicochemical Properties of GA- and MD-Based MFE Microcapsules
3.3.2. Total Bioactive Analysis of GA- and MD-Based MFE Microcapsules
3.3.3. Microstructural Analysis of GA- and MD-Based MFE Microcapsules
4. Conclusions
Author Contributions
Funding
Institutional Review Board Statement
Informed Consent Statement
Data Availability Statement
Acknowledgments
Conflicts of Interest
References
- Janarny, G.; Ranaweera, K.; Gunathilake, K. Antioxidant activities of hydro-methanolic extracts of Sri Lankan edible flowers. Biocatal. Agric. Biotechnol. 2021, 35, 102081. [Google Scholar] [CrossRef]
- Walia, A.; Gupta, A.K.; Sharma, V. Role of bioactive compounds in human health. Acta Sci. Med. Sci. 2019, 3, 25–33. [Google Scholar]
- Drabińska, N.; Jeż, M.; Nogueira, M. Variation in the Accumulation of Phytochemicals and Their Bioactive Properties among the Aerial Parts of Cauliflower. Antioxidants 2021, 10, 1597. [Google Scholar] [CrossRef] [PubMed]
- Ahmad Shiekh, K.; Odunayo Olatunde, O.; Zhang, B.; Huda, N.; Benjakul, S. Pulsed electric field assisted process for extraction of bioactive compounds from custard apple (Annona squamosa) leaves. Food Chem. 2021, 359, 129976. [Google Scholar] [CrossRef] [PubMed]
- Spinelli, S. Study of Microencapsulated Bioactive Compounds in Food Products. 2016. Available online: https://hdl.handle.net/11369/363063 (accessed on 29 August 2015).
- Kaimainen, M.; Järvenpää, E.; Huopalahti, R. Enzyme-assisted oil extraction of lutein from marigold (Tagetes erecta) flowers and stability of lutein during storage. Int. J. Agric. Food Res. 2015, 4, 11–19. [Google Scholar] [CrossRef]
- Ćetković, G.; Djilas, S.; Čanadanović-Brunet, J.; Tumbas Šaponjac, V. Antioxidant properties of marigold extracts. Food Res. Int. 2004, 37, 643–650. [Google Scholar] [CrossRef]
- Chauhan, A.S.; Chen, C.-W.; Singhania, R.R.; Tiwari, M.; Sartale, R.G.; Dong, C.-D.; Patel, A.K. Valorizations of Marigold Waste for High-Value Products and Their Industrial Importance: A Comprehensive Review. Resources 2022, 11, 91. [Google Scholar] [CrossRef]
- Priyanka, D.; Shalini, T.; Navneet, V.K. A brief study on marigold (Tagetes species): A review. Int. Res. J. Pharm. 2013, 4, 43–48. [Google Scholar]
- Usman, I.; Hussain, M.; Imran, A.; Afzaal, M.; Saeed, F.; Javed, M.; Afzal, A.; Ashfaq, I.; Al Jbawi, E.; Saewan, S. Traditional and innovative approaches for the extraction of bioactive compounds. Int. J. Food Prop. 2022, 25, 1215–1233. [Google Scholar] [CrossRef]
- Azmir, J.; Zaidul IS, M.; Rahman, M.; Sharif, K.; Mohamed, A.; Sahena, F.; Jahurul, M.H.A.; Ghafoor, K.; Norulaini, N.A.N.; Omar, A. Techniques for extraction of bioactive compounds from plant materials: A review. J. Food Eng. 2013, 117, 426–436. [Google Scholar] [CrossRef]
- Otles, S. Handbook of Food Analysis Instruments; CRC Press: Boca Raton, FL, USA, 2016. [Google Scholar]
- Insang, S.; Kijpatanasilp, I.; Jafari, S.; Assatarakul, K. Ultrasound-assisted extraction of functional compound from mulberry (Morus alba L.) leaf using response surface methodology and effect of microencapsulation by spray drying on quality of optimized extract. Ultrason. Sonochem. 2021, 82, 105806. [Google Scholar] [CrossRef] [PubMed]
- Calderón-Oliver, M.; Ponce-Alquicira, E. The Role of Microencapsulation in Food Application. Molecules 2022, 27, 1499. [Google Scholar] [CrossRef] [PubMed]
- Šeregelj, V.N.; Ćetković, G.S.; Čanadanović-Brunet, J.M.; Tumbas-Šaponjac, V.T.; Vulić, J.J.; Stajčić, S.S. Extraction and encapuslation of bioactive compounds from carrots. Acta Period. Technol. 2017, 48, 261–273. [Google Scholar] [CrossRef]
- Saénz, C.; Tapia, S.; Chávez, J.; Robert, P. Microencapsulation by spray drying of bioactive compounds from cactus pear (Opuntia ficus-indica). Food Chem. 2009, 114, 616–622. [Google Scholar] [CrossRef]
- Jafari, S.; Karami, Z.; Shiekh, K.A.; Kijpatanasilp, I.; Worobo, R.W.; Assatarakul, K. Ultrasound-Assisted Extraction of Bioactive Compounds from Cocoa Shell and Their Encapsulation in Gum Arabic and Maltodextrin: A Technology to Produce Functional Food Ingredients. Foods 2023, 12, 412. [Google Scholar] [CrossRef] [PubMed]
- Gonelimali, F.D.; Lin, J.; Miao, W.; Xuan, J.; Charles, F.; Chen, M.; Hatab, S.R. Antimicrobial Properties and Mechanism of Action of Some Plant Extracts Against Food Pathogens and Spoilage Microorganisms. Front. Microbiol. 2018, 9, 1639. [Google Scholar] [CrossRef]
- Ramakrishnan, Y.; Adzahan, N.M.; Yusof, Y.A.; Muhammad, K. Effect of wall materials on the spray drying efficiency, powder properties and stability of bioactive compounds in tamarillo juice microencapsulation. Powder Technol. 2018, 328, 406–414. [Google Scholar] [CrossRef]
- Sarabandi, K.; Peighambardoust, S.H.; Sadeghi, A.; Samaei, S. Effect of different carriers on microstructure and physical characteristics of spray dried apple juice concentrate. J. Food Sci. Technol. 2019, 55, 3098–3109. [Google Scholar] [CrossRef]
- Biswas, A.K.; Sahoo, J.; Chatli, M.K. A simple UV-Vis spectrophotometric method for determination of β-carotene content in raw carrot, sweet potato and supplemented chicken meat nuggets. LWT Food Sci. Technol. 2011, 44, 1809–1813. [Google Scholar] [CrossRef]
- Brand-Williams, W.; Cuvelier, M.E.; Burset, C. Use of a free radical method to evaluate antioxidant activity. LWT Food Sci. Technol. 1995, 28, 25–30. [Google Scholar] [CrossRef]
- Benzie, I.F.; Strain, J.J. The ferric reducing ability of plasma (FRAP) as a measure of “antioxidant power”: The FRAP assay. Anal. Biochem. 1996, 239, 70–76. [Google Scholar] [CrossRef]
- Baharuddin, N.A.F.; Nordin, M.F.M.; Morad, N.A.; Aris, N.I.A.; Yunus, M.A.C. Total phenolic, flavonoid content and antioxidant activity of Clinacanthus nutans leaves by water-based ultrasonic assisted extraction. Malays. J. Anal. Sci. 2018, 22, 659–666. [Google Scholar]
- Yıkmış, S. Optimization of uruset apple vinegar production using response surface methodology for the enhanced extraction of bioactive substances. Foods 2019, 8, 107. [Google Scholar] [CrossRef]
- Kobus-Cisowska, J.; Szczepaniak, O.; Szymanowska-Powałowska, D.; Piechocka, J.; Szulc, P.; Dziedziński, M. Antioxidant potential of various solvent extract from Morus alba fruits and its major polyphenols composition. Ciência Rural 2019, 50, 17. [Google Scholar] [CrossRef]
- Chen, X.; Ding, J.; Ji, D.; He, S.; Ma, H. Optimization of ultrasonic-assisted extraction conditions for bioactive components from coffee leaves using the Taguchi design and response surface methodology. J. Food Sci. 2020, 85, 1742–1751. [Google Scholar] [CrossRef]
- Wen, C.; Zhang, J.; Zhang, H.; Dzah, C.S.; Zandile, M.; Duan, Y.; Ma, H.; Luo, X. Advances in ultrasound assisted extraction of bioactive compounds from cash crops—A review. Ultrason. Sonochem. 2018, 48, 538–549. [Google Scholar] [CrossRef]
- Salehi, B.; Venditti, A.; Sharifi-Rad, M.; Kręgiel, D.; Sharifi-Rad, J.; Durazzo, A.; Lucarini, M.; Santini, A.; Souto, E.B.; Novellino, E.; et al. The Therapeutic Potential of Apigenin. Int. J. Mol. Sci. 2019, 20, 1305. [Google Scholar] [CrossRef]
- Liyana-Pathirana, C.M.; Shahidi, F. Antioxidant properties of commercial soft and hard winter wheats (Triticum aestivum L.) and their milling fractions. J. Sci. Food Agric. 2006, 86, 477–485. [Google Scholar] [CrossRef]
- Sungthong, B.; Phadungkit, M. Anti-tyrosinase and DPPH radical scavenging activities of selected Thai herbal extracts traditionally used as skin toner. Pharmacogn. J. 2015, 7, 97–101. [Google Scholar] [CrossRef]
- Akowuah, G.A.; Mariam, A.; Chin, J.H. The effect of extraction temperature on total phenols and antioxidant activity of Gynura procumbens leaf. Pharmacogn. Mag. 2009, 5, 81–85. [Google Scholar]
- Umair, M.; Jabbar, S.; Nasiru, M.M.; Lu, Z.; Zhang, J.; Abid, M.; Murtaza, M.A.; Kieliszek, M.; Zhao, L. Ultrasound-assisted extraction of carotenoids from carrot pomace and their optimization through response surface methodology. Molecules 2021, 26, 6763. [Google Scholar] [CrossRef]
- Jiao, S.; Li, Y.; Wang, Z.; Sun-Waterhouse, D.; Waterhouse, G.I.; Liu, C.; Wang, X. Optimization of enzyme-assisted extraction of bioactive-rich juice from Chaenomeles sinensis (Thouin) Koehne by response surface methodology. J. Food Process. Preserv. 2020, 44, e14638. [Google Scholar] [CrossRef]
- De Zoysa, M.H.N.; Rathnayake, H.; Hewawasam, R.P.; Wijayaratne, W.M.D.G.B. Determination of in vitro antimicrobial activity of five Sri Lankan medicinal plants against selected human pathogenic bacteria. Int. J. Microbiol. 2019, 2019, 7431439. [Google Scholar] [CrossRef]
- Breijyeh, Z.; Jubeh, B.; Karaman, R. Resistance of Gram-Negative Bacteria to Current Antibacterial Agents and Approaches to Resolve It. Molecules 2020, 25, 1340. [Google Scholar] [CrossRef]
- Pudziuvelyte, L.; Marksa, M.; Jakstas, V.; Ivanauskas, L.; Kopustinskiene, D.M.; Bernatoniene, J.J.M. Microencapsulation of elsholtzia ciliata herb ethanolic extract by spray-drying: Impact of resistant-maltodextrin complemented with sodium caseinate, skim milk, and beta-cyclodextrin on the quality of spray-dried powders. Molecules 2019, 24, 1461. [Google Scholar] [CrossRef]
- Murugesan, R.; Orsat, V. Spray drying of elderberry (Sambucus nigra L.) juice to maintain its phenolic content. Drying Technol. 2011, 29, 1729–1740. [Google Scholar] [CrossRef]
- Rajabi, H.; Ghorbani, M.; Jafari, S.M.; Mahoonak, A.S.; Rajabzadeh, G. Retention of saffron bioactive components by spray drying encapsulation using maltodextrin, gum Arabic and gelatin as wall materials. Food Hydrocoll. 2015, 51, 327–337. [Google Scholar] [CrossRef]
- Kalušević, A.; Lević, S.; Čalija, B.; Pantić, M.; Belović, M.; Pavlović, V.; Bugarski, B.; Milić, J.; Žilić, S.; Nedović, V. Microencapsulation of anthocyanin-rich black soybean coat extract by spray drying using maltodextrin, gum Arabic and skimmed milk powder. J. Microencapsul. 2017, 34, 475–487. [Google Scholar] [CrossRef]
- Pitalua, E.; Jimenez, M.; Vernon-Carter, E.; Beristain, C. Antioxidative activity of microcapsules with beetroot juice using gum Arabic as wall material. Food Bioprod. Process. 2010, 88, 253–258. [Google Scholar] [CrossRef]
- Cano-Higuita, D.M.; Vélez HA, V.; Telis, V.R.N. Microencapsulation of turmeric oleoresin in binary and ternary blends of gum Arabic, maltodextrin and modified starch. Ciência Agrotecnol. 2015, 39, 173–182. [Google Scholar] [CrossRef]
- Bernstein, A.; Noreña, C.P.Z. Encapsulation of red cabbage (Brassica oleracea L. var. capitata L. f. rubra) anthocyanins by spray drying using different encapsulating agents. Braz. Arch. Biol. Technol. 2015, 58, 944–952. [Google Scholar]

| Independent Variables | Independent Variable Codes | Level | ||
|---|---|---|---|---|
| −1 | 0 | 1 | ||
| Ethanol concentration (%) | A | 60 | 80 | 100 |
| Extraction temperature (°C) | B | 30 | 40 | 50 |
| Ultrasonication tim (min) | C | 5 | 10 | 15 |
| Independent Variables | Responses | |||||||
|---|---|---|---|---|---|---|---|---|
| Run | Concentration (%) | Temperature (°C) | Time (min) | TPC (mg GAE/ 100 g Dry wt.) | TFC (mg QE/ 100 g Dry wt.) | DPPH (mM Trolox/ 100 g Dry wt.) | FRAP (mM Trolox/ 100 g Dry wt.) | Carotenoid Content (mg Carotenoid/ 100 g Dry wt.) |
| 1 | 80 | 50 | 15 | 72.38 | 95.73 | 610.50 | 4627.37 | 368.23 |
| 2 | 100 | 30 | 10 | 33.59 | 37.83 | 606.75 | 750.74 | 49.51 |
| 3 | 80 | 40 | 10 | 71.28 | 66.30 | 624.25 | 3364.21 | 288.62 |
| 4 | 80 | 40 | 10 | 70.29 | 47.68 | 625.50 | 2995.79 | 266.23 |
| 5 | 100 | 40 | 15 | 69.75 | 76.19 | 621.44 | 1722.11 | 137.96 |
| 6 | 80 | 40 | 10 | 74.14 | 49.36 | 643.62 | 2501.05 | 323.17 |
| 7 | 80 | 30 | 5 | 34.69 | 17.45 | 609.25 | 4585.26 | 414.67 |
| 8 | 80 | 40 | 10 | 72.71 | 57.83 | 644.87 | 2869.47 | 294.69 |
| 9 | 80 | 50 | 5 | 72.71 | 56.72 | 622.37 | 1869.47 | 312.94 |
| 10 | 100 | 50 | 10 | 74.14 | 55.73 | 627.37 | 7364.21 | 79.36 |
| 11 | 60 | 40 | 5 | 79.19 | 48.37 | 634.25 | 2880.00 | 292.48 |
| 12 | 100 | 40 | 5 | 91.94 | 92.14 | 623.31 | 1995.79 | 231.12 |
| 13 | 80 | 40 | 10 | 75.20 | 64.30 | 634.56 | 2932.63 | 266.23 |
| 14 | 60 | 50 | 10 | 69.31 | 55.24 | 615.81 | 9048.42 | 95.12 |
| 15 | 60 | 40 | 15 | 70.46 | 50.85 | 633.62 | 2427.37 | 55.04 |
| 16 | 60 | 30 | 10 | 31.39 | 14.78 | 581.12 | 1039.16 | 184.68 |
| 17 | 80 | 30 | 15 | 34.14 | 18.33 | 607.69 | 2422.32 | 319.30 |
| TPC (mg GAE/100 g Dry wt.) | DPPH (mM Trolox/100 g Dry wt.) | |||||||
| Source | Sum of Squares | df | Mean Square | p-Value | Sum of Squares | df | Mean Squares | p-Value |
| Model | 5361.08 | 9 | 595.68 | 0.0001 | 2879.70 | 9 | 319.97 | 0.16 |
| A | 45.44 | 1 | 45.44 | 0.17 | 24.72 | 1 | 24.72 | 0.69 |
| B | 2992.49 | 1 | 2992.49 | 0.0001 | 634.57 | 1 | 634.57 | 0.08 |
| C | 126.51 | 1 | 126.51 | 0.04 | 31.75 | 1 | 31.75 | 0.66 |
| AB | 1.74 | 1 | 1.74 | 0.77 | 49.44 | 1 | 49.44 | 0.58 |
| AC | 45.30 | 1 | 45.30 | 0.17 | 0.39 | 1 | 0.39 | 0.96 |
| BC | 0.01 | 1 | 0.01 | 0.98 | 26.59 | 1 | 26.59 | 0.69 |
| A2 | 14.69 | 1 | 14.69 | 0.41 | 129.55 | 1 | 129.55 | 0.38 |
| B2 | 2129.0 | 1 | 2129.0 | 0.0001 | 1901.32 | 1 | 1901.32 | 0.01 |
| C2 | 44.24 | 1 | 44.24 | 0.17 | 3.11 | 1 | 3.11 | 0.89 |
| Residual | 132.75 | 7 | 18.96 | 1040.41 | 7 | 148.63 | ||
| Lack of Fit | 116.64 | 3 | 38.88 | 0.03 | 663.45 | 3 | 221.15 | 0.21 |
| Pure Error | 16.11 | 4 | 4.03 | 376.95 | 4 | 94.24 | ||
| Cor Total | 5493.84 | 16 | 3920.11 | 16 | ||||
| R2 | 0.97 | 0.73 | ||||||
| Adj-R2 | 0.94 | 0.39 | ||||||
| FRAP (mM Trolox/100 g Dry wt.) | TFC (mg QE/100 g Dry wt.) | |||||||
| Source | Sum of Squares | df | Mean Squares | p-Value | Sum of Squares | df | Mean Squares | p-Value |
| Model | 4.43 + 07 | 9 | 4.92 + 06 | 0.42 | 7147.90 | 9 | 794.21 | 0.04 |
| A | 1.59 + 06 | 1 | 1.59 + 06 | 0.56 | 1073.51 | 1 | 1073.51 | 0.05 |
| B | 2.49 + 07 | 1 | 2.49 + 07 | 0.04 | 3829.80 | 1 | 3829.80 | 0.0028 |
| C | 2157.21 | 1 | 2157.21 | 0.98 | 87.20 | 1 | 87.20 | 0.52 |
| AB | 4.87 + 05 | 1 | 4.87 + 05 | 0.74 | 127.21 | 1 | 127.21 | 0.44 |
| AC | 800.5 + 54 | 1 | 800.5 + 54 | 0.97 | 84.96 | 1 | 84.96 | 0.52 |
| BC | 6.05 + 06 | 1 | 6.05 + 06 | 0.27 | 363.47 | 1 | 363.47 | 0.21 |
| A2 | 2.61 + 05 | 1 | 2.61 + 05 | 0.81 | 13.85 | 1 | 13.85 | 0.79 |
| B2 | 7.89 + 06 | 1 | 7.89 + 06 | 0.21 | 1366.44 | 1 | 1366.44 | 0.03 |
| C2 | 3.61 + 06 | 1 | 3.61 + 06 | 0.38 | 267.97 | 1 | 267.97 | 0.27 |
| Residual | 2.92 + 07 | 7 | 4.18 + 06 | 1326.53 | 7 | 1326.53 | ||
| Lack of Fit | 2.89 + 07 | 3 | 9.62 + 06 | 0.0003 | 1040.66 | 3 | 346.89 | 0.08 |
| Pure Error | 3.80 + 05 | 4 | 95,124.65 | 285.86 | 4 | 71.47 | ||
| Cor Total | 7.36 + 07 | 16 | 8474.43 | 16 | ||||
| R2 | 0.60 | 0.84 | ||||||
| Adj-R2 | 0.09 | 0.64 | ||||||
| Carotenoid Content (mg Carotenoid/100 g Dry wt.) | ||||||||
| Source | Sum of Squares | df | Mean Squares | p-Value | ||||
| Model | 1.89 + 05 | 9 | 20,967.33 | 0.01 | ||||
| A | 2091.99 | 1 | 2091.99 | 0.38 | ||||
| B | 1582.19 | 1 | 1582.19 | 0.44 | ||||
| C | 17,176.18 | 1 | 17,176.18 | 0.03 | ||||
| AB | 3565.06 | 1 | 3565.06 | 0.26 | ||||
| AC | 5205.23 | 1 | 5205.25 | 0.18 | ||||
| BC | 5674.03 | 1 | 5674.03 | 0.16 | ||||
| A2 | 1.366 + 05 | 1 | 1.37 + 05 | 0.0001 | ||||
| B2 | 127.09 | 1 | 127.09 | 0.82 | ||||
| C2 | 21,519.70 | 1 | 21,519.70 | 0.02 | ||||
| Residual | 16,505.75 | 7 | 2357.96 | |||||
| Lack of Fit | 14,275.60 | 3 | 4758.53 | 0.03 | ||||
| Pure Error | 2230.15 | 4 | 557.54 | |||||
| Cor Total | 2.052 + 05 | 16 | ||||||
| R2 | 0.92 | |||||||
| Adj-R2 | 0.82 | |||||||
| Bioactive Properties | ||||||||||
|---|---|---|---|---|---|---|---|---|---|---|
| Factor | TPC | p-Values | TFC | p-Values | DPPH | p-Values | FRAP | p-Values | Carotenoid | p-Values |
| Intercept | 72.73 | 57.10 | 634.56 | 2932.63 | 287.79 | |||||
| Linear | ||||||||||
| A | 2.38 | 0.17 | 11.58 | 0.05 | 1.76 | 0.70 | −445.26 | 0.56 | −16.17 | 0.38 |
| B | 19.34 | <0.0001 | 21.88 | 0.0028 | 8.91 | 0.08 | 1764 | 0.04 | −14.06 | 0.44 |
| C | −3.98 | 0.04 | 3.30 | 0.52 | −1.99 | 0.66 | −16.42 | 0.98 | −46.34 | 0.03 |
| Cross product | ||||||||||
| AB | 0.66 | 0.77 | −5.64 | 0.44 | −3.52 | 0.58 | −348.95 | 0.74 | 29.85 | 0.26 |
| AC | −3.37 | 0.17 | −4.61 | 0.52 | −0.31 | 0.96 | 44.74 | 0.97 | 36.07 | 0.18 |
| BC | 0.051 | 0.98 | 9.53 | 0.21 | −2.58 | 0.69 | 1230.21 | 0.27 | 37.66 | 0.16 |
| Quadratic | ||||||||||
| A2 | 1.87 | 0.41 | 1.81 | 0.79 | −5.55 | 0.38 | 249.10 | 0.81 | −180.13 | 0.0001 |
| B2 | −22.49 | <0.0001 | −18.01 | 0.03 | −21.25 | 0.009 | 1368.89 | 0.21 | −5.49 | 0.82 |
| C2 | 3.24 | 0.17 | 7.98 | 0.27 | −0.86 | 0.89 | −925.42 | 0.38 | 71.49 | 0.02 |
| Treatments | ||||
|---|---|---|---|---|
| Parameters | 20% GAM (1:2) | 20% GAM (1:3) | 45% MDM (1:1) | 45% MDM (1:2) |
| Yield (%) | 53.59 ± 0.70 d | 56.15 ± 0.73 c | 61.15 ± 0.58 b | 79.20 ± 0.56 a |
| Moisture content (%) | 4.42 ± 0.18 a | 3.45 ± 0.13 b | 4.35 ± 0.13 a | 3.19 ± 2.05 b |
| Water activity | 0.12 ± 0.03 ab | 0.15 ± 0.07 a | 0.12 ± 0.03 ab | 0.10 ± 0.04 b |
| Color values | ||||
| L* | 61.46 ± 1.55 c | 58.16 ± 3.81 d | 73.18 ± 1.51 a | 71.27 ± 1.39 b |
| a* | −4.47 ± 0.17 b | −3.17 ± 0.13 a | −5.99 ± 0.00 c | −5.23 ± 0.11 c |
| b* | 30.45 ± 1.59 a | 25.09 ± 1.53 b | 24.46 ± 0.61 c | 19.02 ± 0.73 d |
| Encapsulation efficiency (%) | 80.79 ± 1.12 b | 80.49 ± 1.85 b | 88.00 ± 1.15 a | 78.05 ± 1.04 c |
| Solubility (%) | 88.41 ± 2.91 bc | 92.73 ± 3.20 ab | 89.31 ± 1.31 b | 92.98 ± 4.22 a |
| TPC (mg GAE/100 g dry wt.) | 627.91 ± 24.86 a | 508.13 ± 9.52 b | 435.24 ± 8.32 c | 304.10 ± 7.06 d |
| TFC (mg QE/100 g dry wt.) | 389.56 ± 9.58 a | 376.73 ± 10.37 b | 282.90 ± 1.53 c | 209.87 ± 4.60 d |
| Carotenoid content (mg carotenoid/100 g dry wt.) | 208.45 ± 2.36 a | 162.75 ± 1.69 b | 55.22 ± 1.94 c | 44.62 ± 2.63 d |
| DPPH (mM Trolox/100 g dry wt.) | 1756.66 ± 28.99 a | 1469.70 ± 31.02 b | 1217.83 ± 22.68 c | 794.50 ± 15.61 d |
| FRAP (mM Trolox/100 g dry wt.) | 4837.89 ± 27.85 a | 4308.07 ± 26.49 b | 3076.49 ± 16.08 c | 2665.96 ± 21.91 d |
Disclaimer/Publisher’s Note: The statements, opinions and data contained in all publications are solely those of the individual author(s) and contributor(s) and not of MDPI and/or the editor(s). MDPI and/or the editor(s) disclaim responsibility for any injury to people or property resulting from any ideas, methods, instructions or products referred to in the content. |
© 2024 by the authors. Licensee MDPI, Basel, Switzerland. This article is an open access article distributed under the terms and conditions of the Creative Commons Attribution (CC BY) license (https://creativecommons.org/licenses/by/4.0/).
Share and Cite
Oo, N.; Shiekh, K.A.; Jafari, S.; Kijpatanasilp, I.; Assatarakul, K. Characterization of Marigold Flower (Tagetes erecta) Extracts and Microcapsules: Ultrasound-Assisted Extraction and Subsequent Microencapsulation by Spray Drying. Foods 2024, 13, 2436. https://doi.org/10.3390/foods13152436
Oo N, Shiekh KA, Jafari S, Kijpatanasilp I, Assatarakul K. Characterization of Marigold Flower (Tagetes erecta) Extracts and Microcapsules: Ultrasound-Assisted Extraction and Subsequent Microencapsulation by Spray Drying. Foods. 2024; 13(15):2436. https://doi.org/10.3390/foods13152436
Chicago/Turabian StyleOo, Nilar, Khursheed Ahmad Shiekh, Saeid Jafari, Isaya Kijpatanasilp, and Kitipong Assatarakul. 2024. "Characterization of Marigold Flower (Tagetes erecta) Extracts and Microcapsules: Ultrasound-Assisted Extraction and Subsequent Microencapsulation by Spray Drying" Foods 13, no. 15: 2436. https://doi.org/10.3390/foods13152436
APA StyleOo, N., Shiekh, K. A., Jafari, S., Kijpatanasilp, I., & Assatarakul, K. (2024). Characterization of Marigold Flower (Tagetes erecta) Extracts and Microcapsules: Ultrasound-Assisted Extraction and Subsequent Microencapsulation by Spray Drying. Foods, 13(15), 2436. https://doi.org/10.3390/foods13152436

